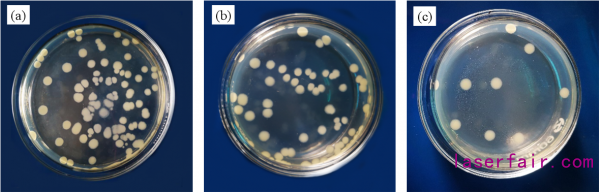

據《激光制造網》了解,日前,華南農業大學生物質3d 打印材料研究中心開發出了具有高光澤和抗菌性能的新型木塑復合材料。
熔融沉積成型3D打印技術具有快速成型和產品個性化等優點,將其應用于制造家具成為近年來的研究熱點。與天然木材相比,木塑復合材料具有成本低,耐腐蝕,壽命長的優點,因此廣泛用于家具,公園長椅和門窗框架中。將木塑復合材料通過熔融沉積成型3D打印技術制備個性化家具是一項具有巨大商業前景的工作。但是,市面上的木塑復合材料的熱性能差,外觀粗糙且無光澤(需要表面涂層),并且抗菌效果差。
為此,華南農業大學生物質3D打印材料研究中心的周武藝和董先明教授課題組聯合清華大學危巖教授課題組以聚乳酸為基體,采用刨花板木粉和微米銅鋅合金(mCu-Zn)顆粒為增強體,通過熔融共混工藝制備了一種新型木塑復合材料,該復合材料具有高光澤和優異的抗菌性能。通過添加mCu-Zn顆粒,進一步提高復合材料的力學性能,使木塑復合材料具有高光澤和優異的抗菌性能。當添加2 wt%的mCu-Zn顆粒時,木塑復合材料的表面光澤度提高了1142.6%,并且復合材料對大腸桿菌的抑菌率達到90.43%。
該新材料有望用于公共場所包括醫院、機場、高鐵站和家具行業等家具制造和防護等領域。
該研究成果發表在國際刊物Polymers, 同時獲得了中國授予專利權,授權公告號:CN110041676B。(F. W. Yang, J. H. Zeng, H. B. Long, J. L. Xiao, Y. Luo, J. Gu, W. Y. Zhou*, Y. Wei, X. M. Dong*. Micrometer Copper-Zinc Alloy Particles-Reinforced Wood Plastic Composites with High Gloss and Antibacterial Properties for 3D Printing[J]. Polymers, 2020, 12(3), 621. https://www.mdpi.com/journal/polymers/special_issues/advances_composite_polymers_3D_printing)


復合材料線材及熔融沉積成型3D打印長絲和家具樣件
新型復合材料抗菌性能測試

發明專利證書
轉載請注明出處。





相關文章
熱門資訊

精彩導讀




關注我們




